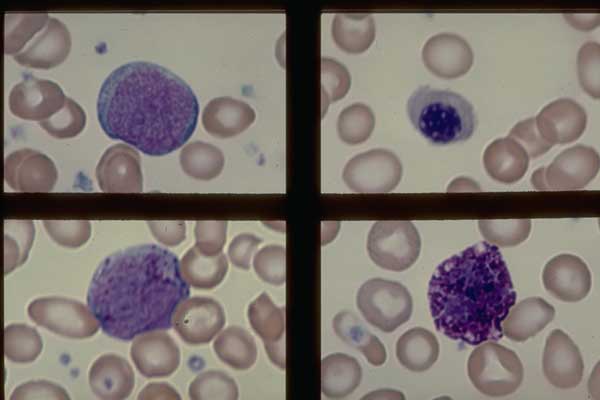
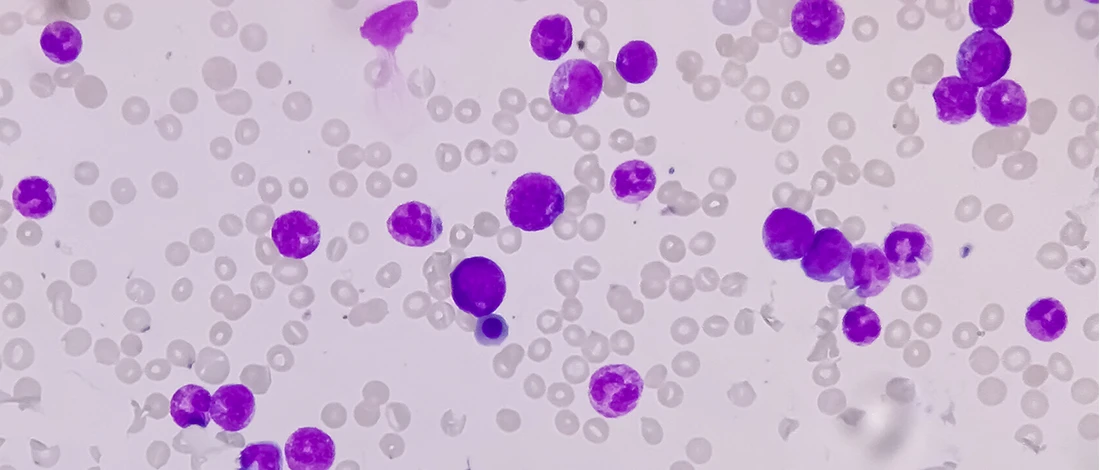
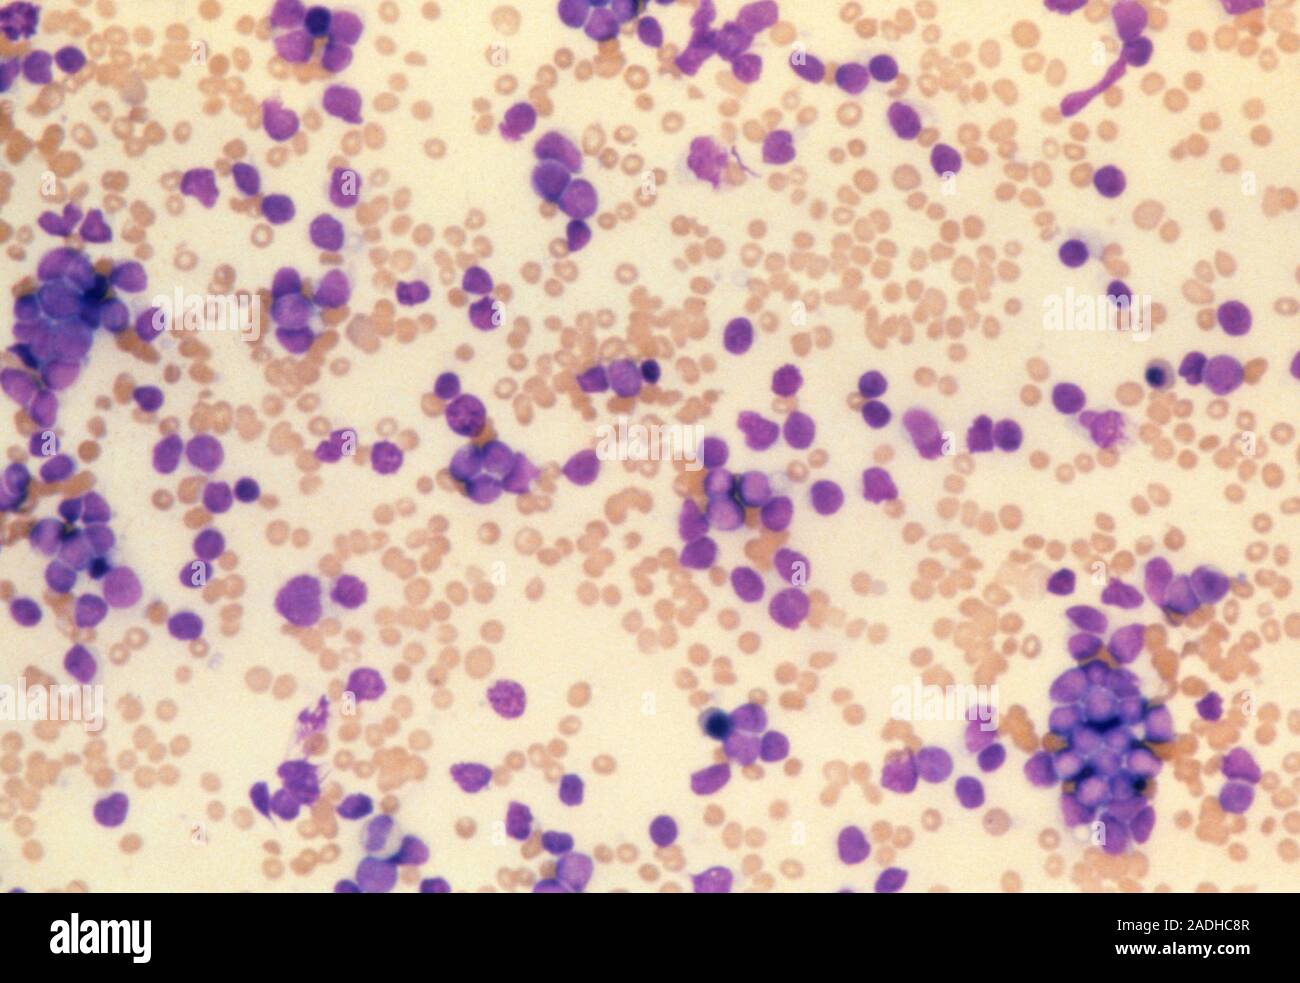

Лейкемия лейкоциты
Лейкемия лейкоциты 112 фотографий
Песни тимы белорусских бабл гам
Сайт школы 91 омск
Горнальский свято николаевский белогорский
Мкоу пионерская
Как завязать нитку перед шитьем
Пассат б3 аам
Школа английского курск
Epic пригласи друга
Скрич роблокс
Полочки над телевизором
Показать результат тиража рапидо о
Строение филина
Разрешенное время ремонта квартиры в москве
Тест на iq для 8 лет
Образовательное учреждение общего назначения
Путинизм ютуб
Сантехника замена сантехники замена стояков
Железноводск эльбрус телефон
Москва игры для плейстейшен
Какие новые отчеты в 2025 году